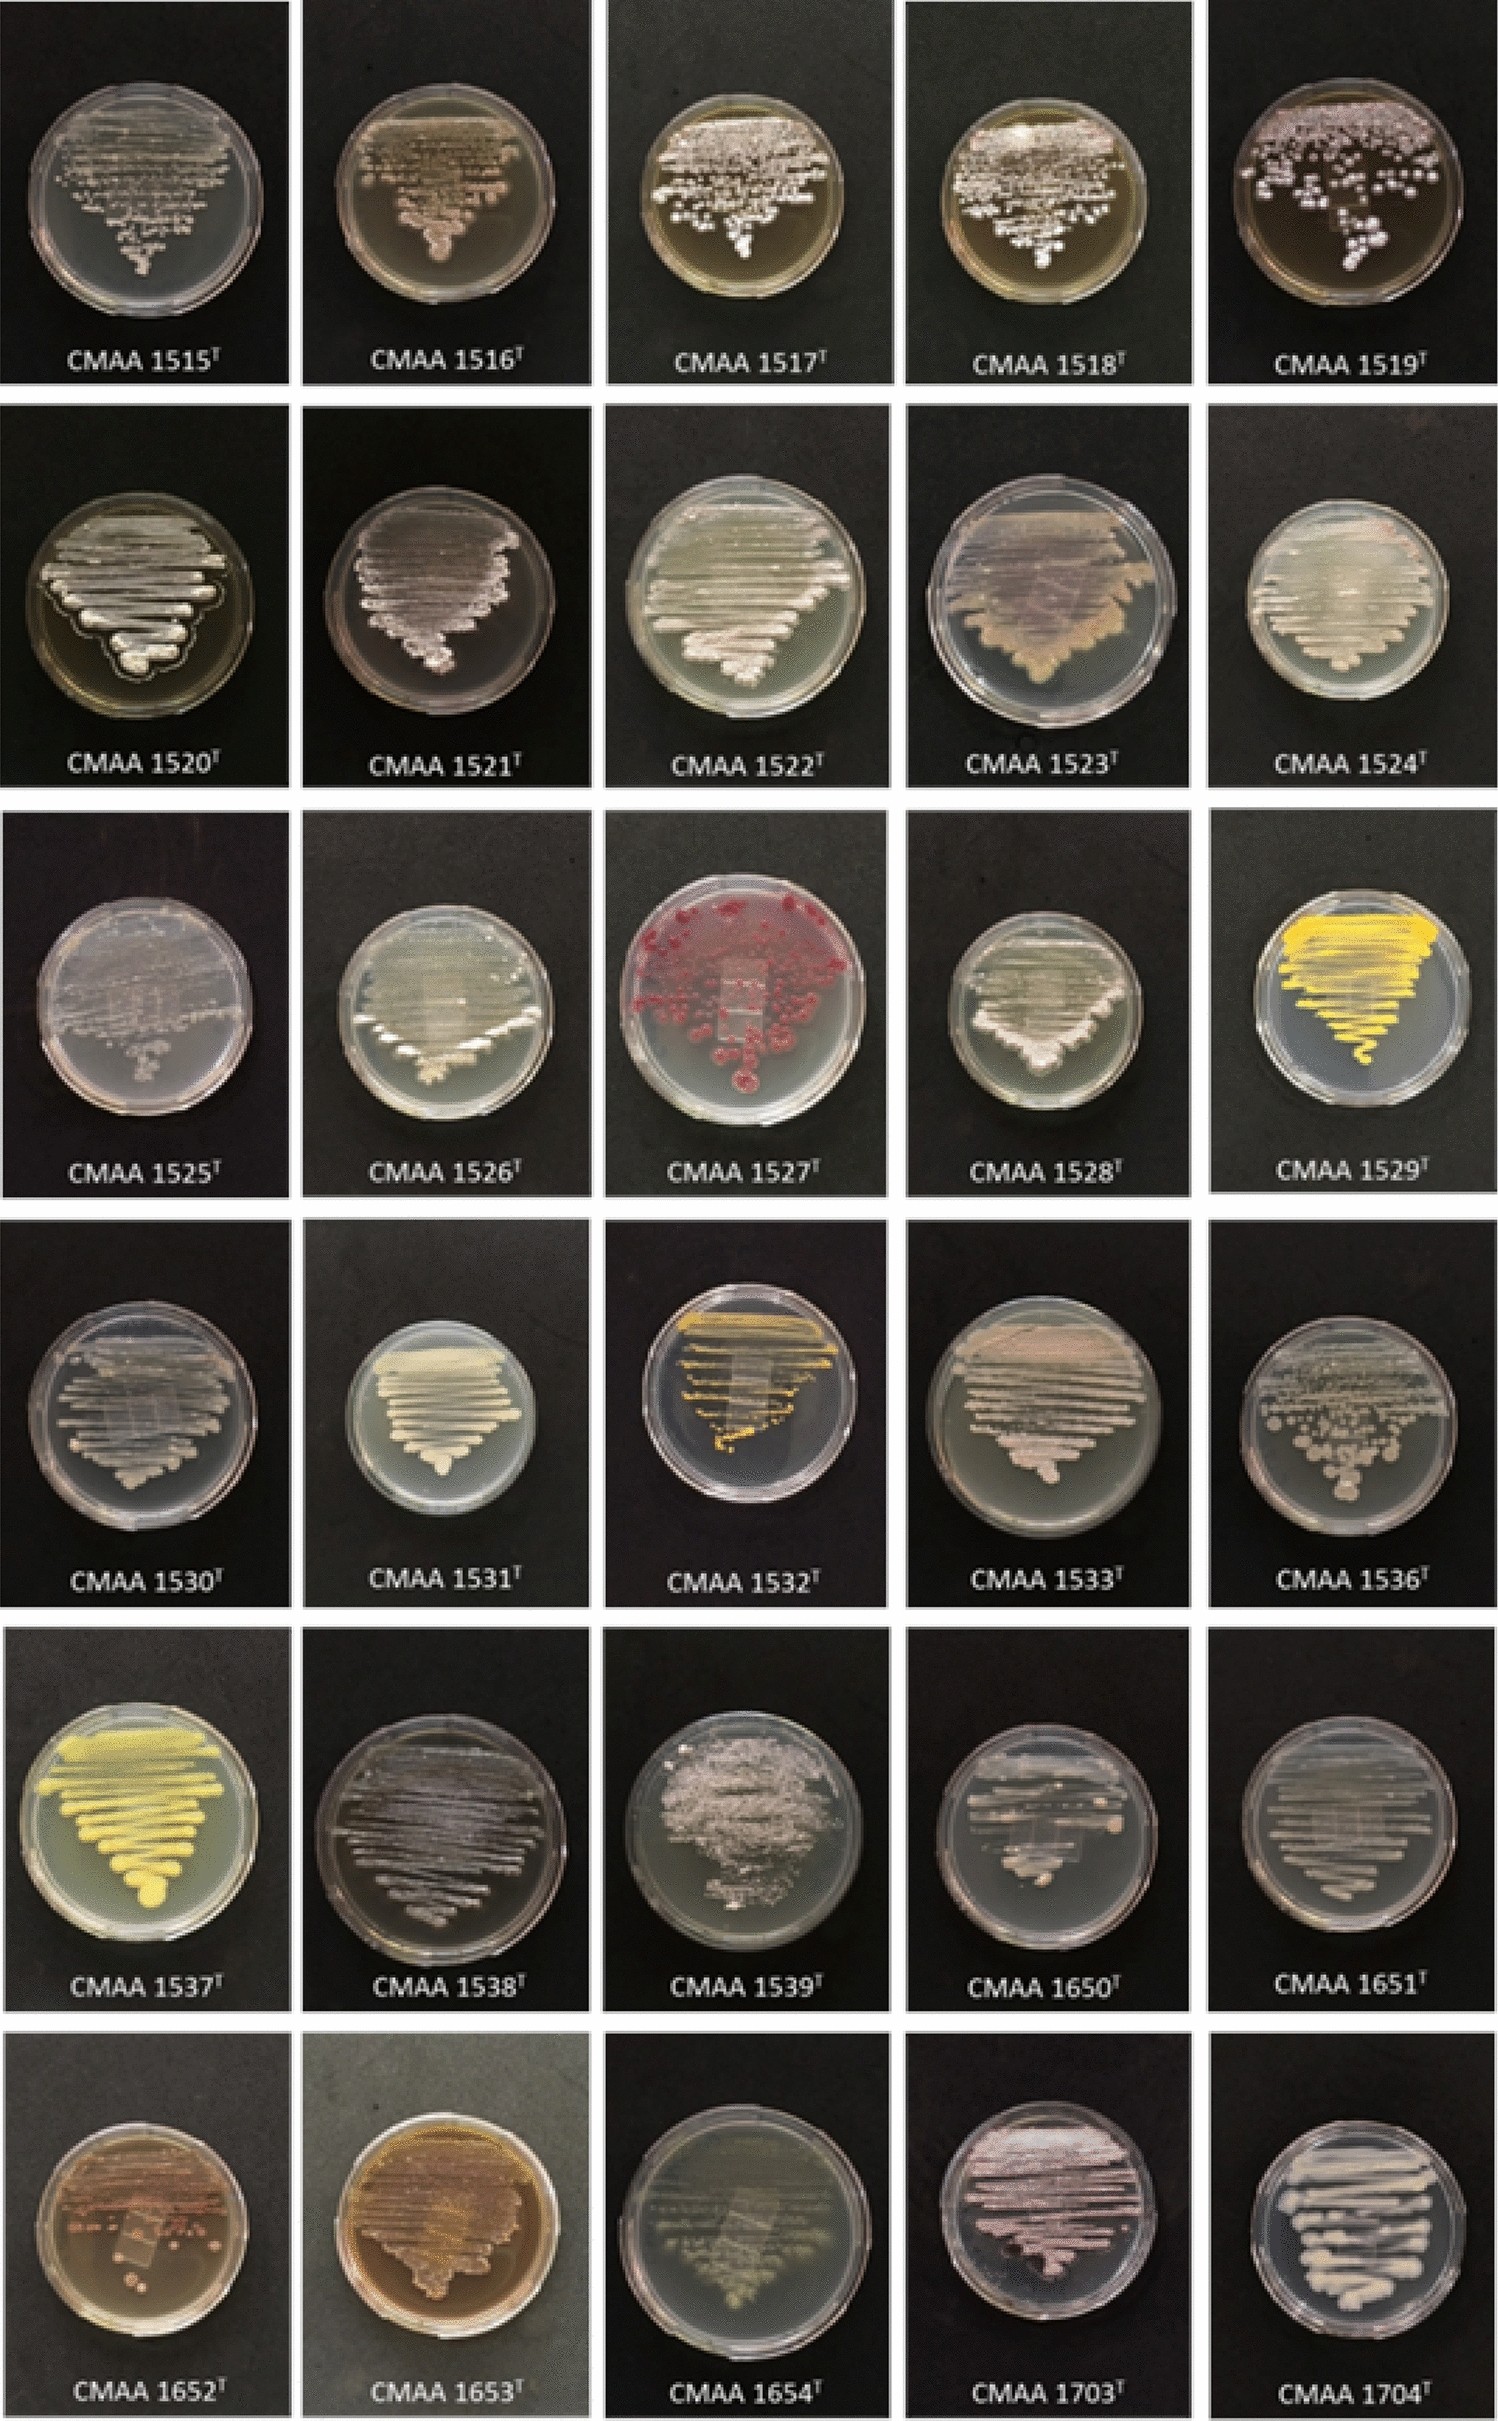
Figure 4

Figure 4
From: Actinobacteria from Antarctica as a source for anticancer discovery

Morphological diversity of Actinobacteria strains isolated from the rhizosphere of Deschampsia antarctica Desv.
From: Actinobacteria from Antarctica as a source for anticancer discovery
Morphological diversity of Actinobacteria strains isolated from the rhizosphere of Deschampsia antarctica Desv.